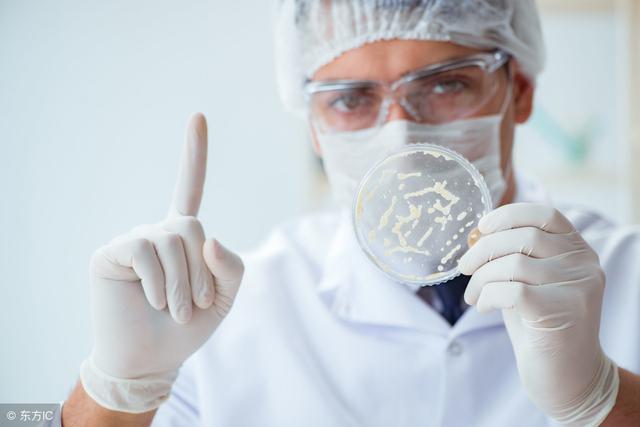

分娩交流:女人生孩子时候遇到的那些尴尬事,你遇到过几件?
怀孕生宝宝 , 对于每一个孕龄女性来说 , 都是件幸福而又欣喜的事情 。 但是一些做了妈妈的女性朋友聊天的时候说生孩子却是女性最狼狈不堪的时候 , 想要优雅地生孩子 , 那是不可能的 。 说到这些 , 很多人都有不同的心得和感受 。 今天我们就来盘点一下女性怀孕生孩子期间 , 究竟会遇到哪些尴尬的事情呢?

----分娩交流:女人生孩子时候遇到的那些尴尬事 , 你遇到过几件?//---- http:// //
1、一阳指:俗称“内检” , 为了了解宫口情况和胎儿位置 , 在分娩前医生会多次进行内检 。 虽然很多产妇都会感觉尴尬 , 但也是不可避免的产检项目 。

----分娩交流:女人生孩子时候遇到的那些尴尬事 , 你遇到过几件?//---- http:// //
2、备皮:俗称“剃阴毛” , 为了方便医生操作和减少细菌 , 不管是顺产还是剖腹产都会进行备皮 , 当然产妇也可以在家让宝爸代劳 , 前提是一定要清理干净 , 否则医生还是会返工的 。
----分娩交流:女人生孩子时候遇到的那些尴尬事 , 你遇到过几件?//---- http:// //
3、男医生:哇塞 , 这个最难为情了 。 产妇裸着下体躺在分娩床上 , 结果来的是男医生 , 这会让很多产妇既尴尬又害羞 。 医生眼里没有性别之分 , 所以产妇还是专心分娩比较重要 。

----分娩交流:女人生孩子时候遇到的那些尴尬事 , 你遇到过几件?//---- http:// //
- 春龙和宝宝■为什么别人生完孩子长高了?轮到自己不增反减?有个问题不能忽略
- #八抓娱#原创女艺人生完二胎得癌症晚期,体内查出8颗肿瘤
- 【儿科医生鲍秀兰】萌娃吃人生中的第一口冰淇淋,小表情萌翻网友:这也太好吃了吧!
- 交流平台■宝宝湿疹与喝的奶粉有关吗?
- 『交流平台』如何让宝宝好好吃饭?
- 人生不容易@出生30小时新生儿被感染,真的存在母婴传播?家里宝贝如何保护?
- [交流平台]宝宝喉梗阻是怎么回事?
- 【交流平台】鱼肝油,宝宝需要吃到几岁?
- 交流平台■婴儿的能吃与不能吃
- #母婴参考#孕期孕妈体重增长维持在这个数,宝宝发育好,顺产分娩也很顺利
